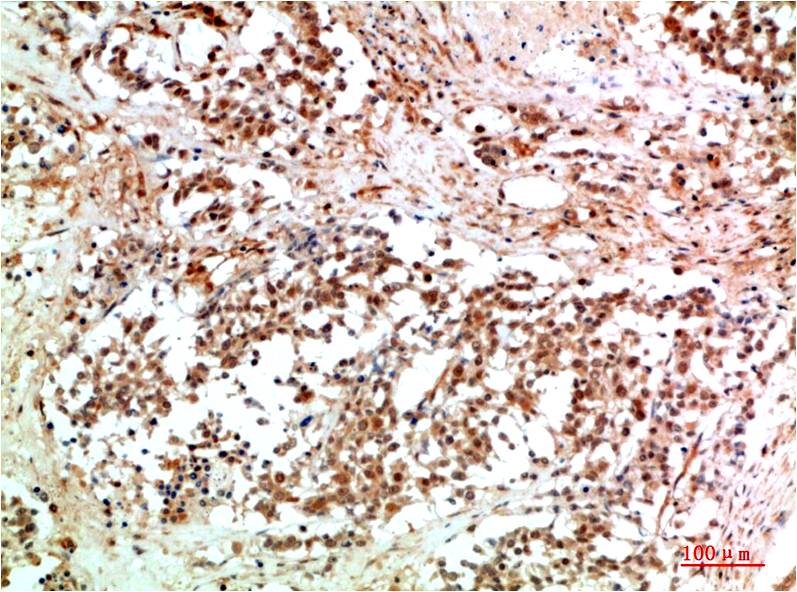

JAK2 Rabbit pAb
 One-click to copy product information
One-click to copy product information$148.00/50µL $248.00/100µL
| 50 µL | $148.00 |
| 100 µL | $248.00 |
Overview
| Product name: | JAK2 Rabbit pAb |
| Reactivity: | Human, Mouse, Rat |
| Alternative Names: | Janus kinase 2,JTK10,Tyrosine protein kinase Jak2, THCYT3 |
| Source: | Rabbit |
| Dilutions: | IHC 1:100-200 |
| Immunogen: | Recombinant Protein |
| Storage: | PBS with 0.02% sodium azide and 50% glycerol pH 7.4. Store at -20°C. Avoid repeated freeze-thaw cycles. |
| Clonality: | Polyclonal |
| Isotype: | IgG |
| Concentration: | 1mg/mL |
| Observed Band: | 120kDa |
| GeneID: | 3717 |
| Human Swiss-Prot No: | O60674 |
| Cellular localization: | Endomembrane system. Nucleus |
| Background: | Members of the Janus family of tyrosine kinases (Jak1, Jak2, Jak3 and Tyk2) are activated by ligands binding to a number of associated cytokine receptors. |

 Manual
Manual